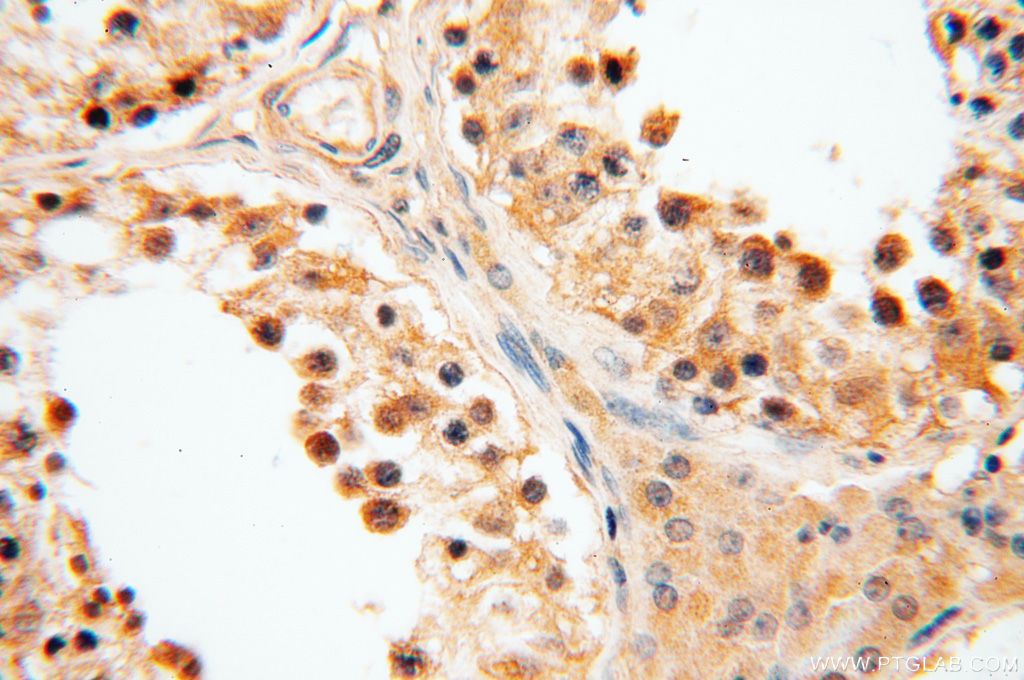

GPD2抗体
产品名称: GPD2抗体
英文名称: GPD2Antibody
产品编号: XY17219-1
产品价格: null
产品产地: 中国/美国
品牌商标: XYbscience
更新时间: 2023-08-17T09:55:27
使用范围: WB,ELISA,IHC-P,IHC-F,IF
- 联系人 : 徐经理
- 地址 : 上海市闵行莘庄工业区春东路508号A1-2F
- 邮编 : 200612
- 所在区域 : 上海
- 电话 : 152****8802 点击查看
- 传真 : 点击查看
- 邮箱 : shxysw02@163.com
- 二维码 : 点击查看
GPD2抗体
XY132Bo21 防御素β103A(DEFβ103A)单克隆抗体 Monoclonal Antibody to Defensin Beta 103A (DEFb103A) Bos taurus; Bovine (Cattle)
XY132Hu21 防御素β103A(DEFβ103A)单克隆抗体 Monoclonal Antibody to Defensin Beta 103A (DEFb103A) Homo sapiens (Hukl)
XY134Hu21 防御素α6(DEFα6)单克隆抗体 Monoclonal Antibody to Defensin Alpha 6, Paneth Cell Specific (DEFa6) Homo sapiens (Hukl)
XY137Hu21 防御素α4(DEFα4)单克隆抗体 Monoclonal Antibody to Defensin Alpha 4, Corticostatin (DEFa4) Homo sapiens (Hukl)
XY140Hu21 γ-谷氨酰基转氨酶5(γGT5)单克隆抗体 Monoclonal Antibody to Gamma-Glutamyltransferase 5 (gGT5) Homo sapiens (Hukl)
XY158Hu21 Saitohin蛋白(STH)单克隆抗体 Monoclonal Antibody to Saitohin (STH) Homo sapiens (Hukl)
XY162Ra21 法尼基二磷酸合酶(FDPS)单克隆抗体 Monoclonal Antibody to Farnesyl Diphosphate Synthase (FDPS) Rattus norvegicus (Rat)
XY171Hu21 干扰素α/β受体2(IFNα/βR2)单克隆抗体 Monoclonal Antibody to Interferon Alpha/Beta Receptor 2 (IFNa/bR2) Homo sapiens (Hukl)
XY174Hu21 前列腺蛋白类脂肪酶B(LIPB)单克隆抗体 Monoclonal Antibody to Lipophilin B, Prostatein Like (LIPB) Homo sapiens (Hukl)
XY175Hu21 脂肪酶H(LIPH)单克隆抗体 Monoclonal Antibody to Lipase H (LIPH) Homo sapiens (Hukl)
XY182Hu21 前蛋白转化酶枯草溶菌素2(PCSK2)单克隆抗体 Monoclonal Antibody to Proprotein Convertase Subtilisin/Kexin Type 2 (PCSK2) Homo sapiens (Hukl)
XY185Hu21 前蛋白转化酶枯草溶菌素5(PCSK5)单克隆抗体 Monoclonal Antibody to Proprotein Convertase Subtilisin/Kexin Type 5 (PCSK5) Homo sapiens (Hukl)
XY189Ra21 前蛋白转化酶枯草溶菌素9(PCSK9)单克隆抗体 Monoclonal Antibody to Proprotein Convertase Subtilisin/Kexin Type 9 (PCSK9) Rattus norvegicus (Rat)
XY190Hu21 前蛋白转化酶枯草溶菌素1(PCSK1)单克隆抗体 Monoclonal Antibody to Proprotein Convertase Subtilisin/Kexin Type 1 (PCSK1) Homo sapiens (Hukl)
XY190Ra21 前蛋白转化酶枯草溶菌素1(PCSK1)单克隆抗体 Monoclonal Antibody to Proprotein Convertase Subtilisin/Kexin Type 1 (PCSK1) Rattus norvegicus (Rat)
XY209Ra21 弹性蛋白酶2A(ELA2A)单克隆抗体 Monoclonal Antibody to Elastase 2A (ELA2A) Rattus norvegicus (Rat)
XY210Hu21 弹性蛋白酶2B(ELA2B)单克隆抗体 Monoclonal Antibody to Elastase 2B (ELA2B) Homo sapiens (Hukl)
XY211Hu21 弹性蛋白酶3A(ELA3A)单克隆抗体 Monoclonal Antibody to Elastase 3A (ELA3A) Homo sapiens (Hukl)
XY212Hu21 弹性蛋白酶3B(ELA3B)单克隆抗体 Monoclonal Antibody to Elastase 3B (ELA3B) Homo sapiens (Hukl)
XY212Ra21 弹性蛋白酶3B(ELA3B)单克隆抗体 Monoclonal Antibody to Elastase 3B (ELA3B) Rattus norvegicus (Rat)
XY213Hu21 糜蛋白酶原B1(CTRB1)单克隆抗体 Monoclonal Antibody to Chymotrypsinogen B1 (CTRB1) Homo sapiens (Hukl)
XY214Hu21 糜蛋白酶原B2(CTRB2)单克隆抗体 Monoclonal Antibody to Chymotrypsinogen B2 (CTRB2) Homo sapiens (Hukl)